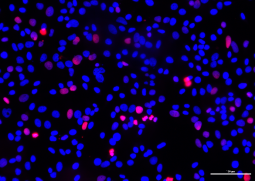
新闻图片4

12 年
手机商铺
公司新闻/正文
773 人阅读发布时间:2024-12-18 16:17
细胞爬片是细胞生物学研究中的常用手段,用于观察细胞形态、进行荧光染色或酶标检测。TUNEL(TdT-mediated dUTP Nick-End Labeling)实验则是检测细胞凋亡的重要方法,它通过标记细胞DNA链断裂产生的3’-OH末端来标记凋亡细胞。用细胞爬片检测细胞凋亡时,细胞容易在实验过程中脱片,影响实验的结果和数据的可信度。今天Elabscience将和大家一起探讨细胞爬片TUNEL实验中脱片产生的原因及影响,并分享有效的防脱片措施。
一、脱片的原因与影响
用细胞爬片进行TUNEL实验,脱片的主要原因可以归结为以下几点:
① 细胞本身的附着力较差,未能牢固附着于玻片表面,导致在洗涤、染色和反应步骤中容易脱落。
② 实验条件不当,导致细胞凋亡过度而脱片。
③ 实验步骤中的固定不当、冲洗过于剧烈、反应温度与时间控制不佳等都可能造成细胞脱片。

图1. 细胞爬片脱片(大鼠肺大动脉内皮细胞,DAPI染色)
脱片的影响体现在多个方面:
首先,脱片会导致玻片上细胞数量减少,影响样本的代表性(图1)。尤其是当细胞脱片较为严重时,玻片上的细胞数量可能不足以进行准确的统计学分析。
其次,脱片还会导致细胞染色不均匀(图2),尤其是在TUNEL实验中,这可能会影响凋亡细胞的检测。脱片引起的细胞分布不均会干扰荧光信号的观察,从而误导实验数据的解读。
为了保证实验结果的稳定性和可靠性,必须采取有效的措施来减少细胞脱片的发生。

图2. 脱片导致荧光信号分布不均(小鼠神经星形胶质细胞,DAPI染色)
二、防止脱片的措施
针对细胞爬片TUNEL实验中脱片的原因,我们可以从以下几个方面优化实验条件,以减少细胞脱片:
1. 选择合适的载玻片
玻片的选择是防止细胞脱片的首要环节。一般建议使用经过特殊处理的载玻片,如聚-L-赖氨酸(Poly-L-lysine)涂覆的玻片或细胞培养专用的玻片。这些玻片通过改性处理增强了细胞在玻片表面的附着力,从而减少实验过程中的脱片现象。此外,也可以考虑使用胶原蛋白涂覆的玻片,这种玻片适用于需要模拟细胞外基质环境的实验。
2. 控制实验条件
设计实验时可以先进行预实验,确定好最佳的实验条件(药物处理浓度、培养时间等),防止细胞因凋亡过度而脱片。

图3. 不同浓度(左10 μm,右5 μm)喜树碱处理的Hela细胞爬片,用一步法TUNEL原位细胞凋亡检测试剂盒(红色,Elab Fluor® 594)(E-CK-A322)染色实验结果
图3中实验结果可以看出,左侧实验条件导致细胞凋亡过度,细胞密度较右图低,凋亡数量比右图高。
因此,设计实验时要设置好处理的条件,防止细胞凋亡过度。如果实验条件无法更改,可以收集培养液中凋亡的细胞均匀涂在爬片上制备成细胞涂片后再进行TUNEL实验,或者选择流式TUNEL检测(推荐:Elabscience®一步法TUNEL流式凋亡检测试剂盒,检测结果可通过流式细胞仪进行分析,更适用悬浮细胞、贴壁细胞的TUNEL检测)。
3. 控制细胞密度
在细胞接种时,应合理控制细胞密度。如果细胞接种过少,细胞之间缺乏相互支持,更容易在实验过程中脱片。因此,根据细胞类型的不同,确定适当的接种密度,使细胞在玻片上能较好地铺展并附着。
4. 进行适当的细胞固定
固定步骤是TUNEL实验中非常关键的一步。通常使用4%的多聚甲醛进行细胞固定,固定时间控制在10-20分钟之间。固定时间过短可能导致细胞未能完全固定,从而在后续的步骤中脱片;而固定时间过长,则可能引起细胞的形态改变导致附着力减弱。因此,应根据细胞类型和实验条件,优化固定时间,以达到最佳的固定效果。
5. 严格控制细胞通透的条件
细胞爬片的通透一般选择0.2%的Triton X-100溶液,如果选择蛋白酶K,可能会导致细胞脱落(图4所示)。

图4. 不同通透方法对比(左图:蛋白酶K通透,右图:0.2%Triton X-100通透)
图4中可以看出,通透对TUNEL实验结果影响显著,细胞爬片的通透剂应选择0.2%Triton X-100。同时还需注意:Triton X-100溶液用PBS稀释,Triton X-100的粘稠高,可提前1-2天配制并放在4℃保存。
6. 采用温和的洗涤方法
洗涤步骤是细胞脱片的高风险环节。建议在洗涤时避免剧烈的搅拌或冲洗,应采用缓慢加液或轻轻倾倒的方式来更换缓冲液。同时,洗涤液的温度应尽量接近室温,避免温差过大引起细胞的应激反应,从而增强细胞的附着稳定性。
希望这些防脱片的处理方法,能为大家的TUNEL实验保驾护航,提升实验的稳定性和数据的可靠性。关于TUNEL实验细胞爬片脱片的介绍到此结束,欢迎关注Elabscience®,解锁更多细胞状态检测实验技巧。